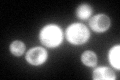
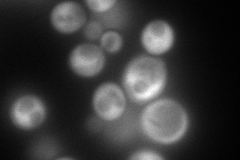
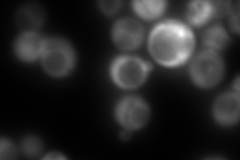
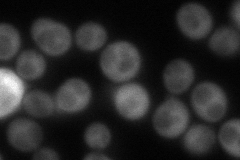
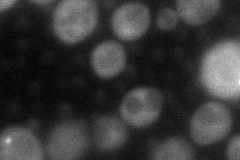

View description
Inosine monophosphate dehydrogenase, catalyzes the first step of GMP biosynthesis, member of a four-gene family in S. cerevisiae, constitutively expressed
Localization:
Intensity:
Fold change:
Significance:
-
C’ GFP library in SD
cytosol105.91 -
N' NOP1pr-GFP in SD
cytosol277.095 -
N' TEF2pr-mCherry in SD
cytosol17.947 -
N' NATIVEpr-GFP in SD
cytosol115.953 -
N' TEF2pr-VC and Cyto-VN in SD
cytosol66.8387 -
C’ GFP library in SD+DTT

cytosol62.50.59Yes -
C’ GFP library in SD+H2O2

cytosol128.251.21No -
C’ GFP library in Starvation Media

cytosol53.080.5Yes -
C’ GFP library on the background of Pup2-DaMP

cytosol -
C’ GFP library on the background of CCT mutant

cytosol118.3411.11725No
